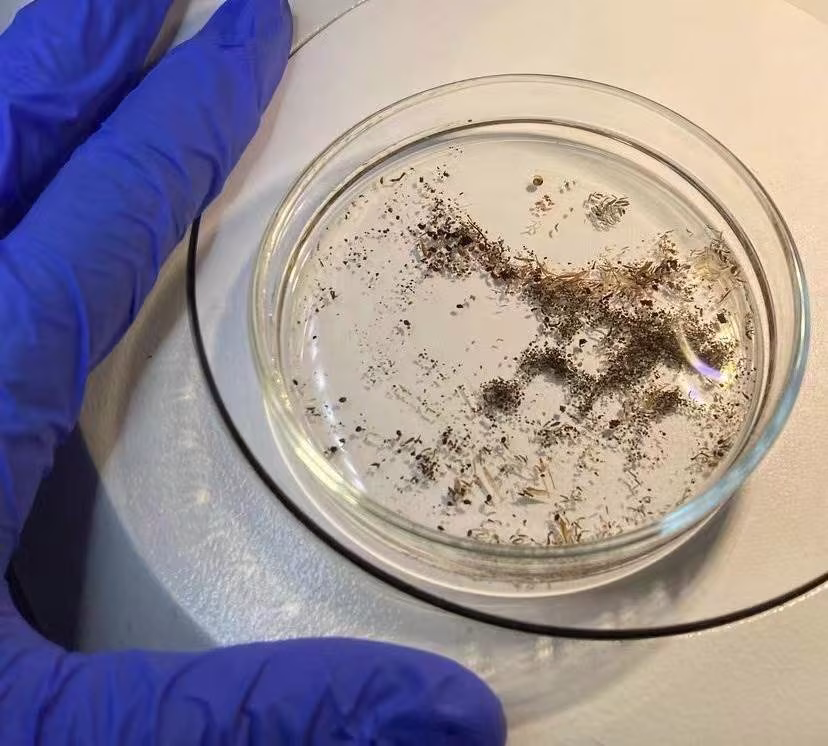

2/7
下一頁
原來蟎蟲最怕它!往床上撒一把,輕輕鬆鬆殺光千萬隻蟎蟲,比太陽暴曬強10000倍
2/7
那麼,究竟是什麼讓這些討厭的小東西聞風喪膽呢?
首先,我們要明白蟎蟲的習性。
蟎蟲是一種喜歡潮濕、陰暗環境的微小生物,它們以人體或動物脫落的皮膚細胞和油脂皮屑為食。
因此,我們的床上用品、地毯、沙發和毛絨玩具,養的寵物貓狗等都是蟎蟲的最愛。
而且蟎蟲的繁殖速度非常快,這也就意味著,如果你的臥室中有蟎蟲,用不了多久,它們就會在整個家大量繁殖,讓你的臥室和客廳沙發地毯等場所變得不再舒適。
 幸山輪 • 330次觀看
幸山輪 • 330次觀看 舒黛葉 • 3K次觀看
舒黛葉 • 3K次觀看 東嫻靜 • 620次觀看
東嫻靜 • 620次觀看 東嫻靜 • 230次觀看
東嫻靜 • 230次觀看 東嫻靜 • 270次觀看
東嫻靜 • 270次觀看 喬峰傳 • 2K次觀看
喬峰傳 • 2K次觀看 舒黛葉 • 890次觀看
舒黛葉 • 890次觀看 史聰珍 • 2K次觀看
史聰珍 • 2K次觀看 東嫻靜 • 120次觀看
東嫻靜 • 120次觀看 舒黛葉 • 3K次觀看
舒黛葉 • 3K次觀看 毛雅菲 • 1K次觀看
毛雅菲 • 1K次觀看 呂純弘 • 300次觀看
呂純弘 • 300次觀看 喬峰傳 • 40次觀看
喬峰傳 • 40次觀看 舒黛葉 • 820次觀看
舒黛葉 • 820次觀看 老臘肉 • 1K次觀看
老臘肉 • 1K次觀看 舒黛葉 • 2K次觀看
舒黛葉 • 2K次觀看 舒黛葉 • 2K次觀看
舒黛葉 • 2K次觀看 毛雅菲 • 820次觀看
毛雅菲 • 820次觀看 毛雅菲 • 580次觀看
毛雅菲 • 580次觀看 毛雅菲 • 790次觀看
毛雅菲 • 790次觀看 舒黛葉 • 2K次觀看
舒黛葉 • 2K次觀看 喬峰傳 • 400次觀看
喬峰傳 • 400次觀看




















